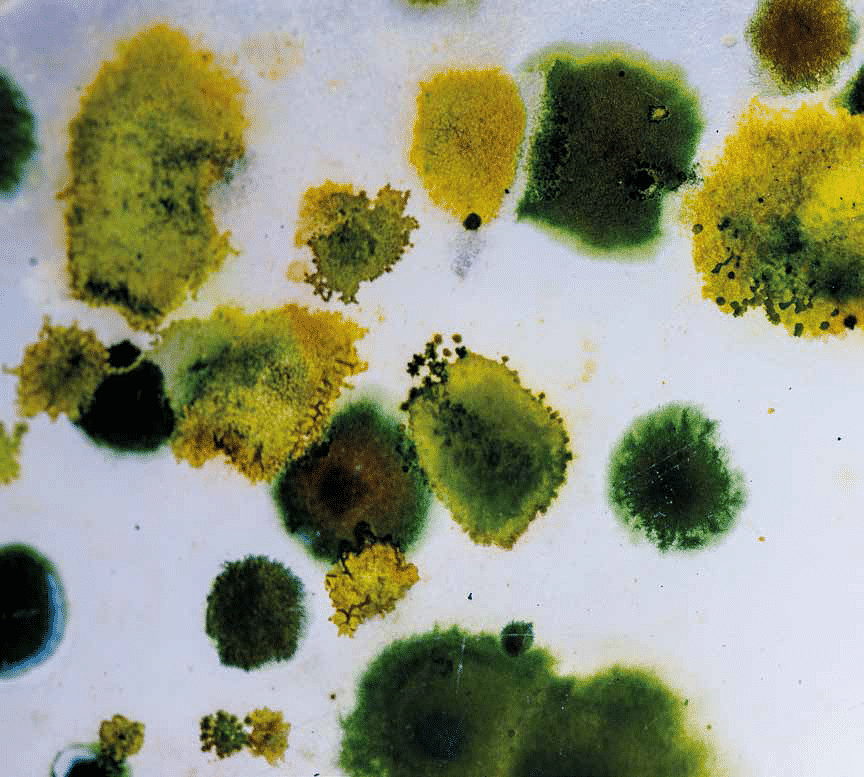

Stresser les microalgues au bénéfice des biotechnologies
Publié par Pôle Science & Société Le Mans Université, le 20 janvier 2026 1
CES MICRO-ORGANISMES SONT PROMETTEURS POUR LA PRODUCTION DE MOLÉCULES D’INTÉRÊT, DONT LE BIOHYDROGÈNE. ENCORE FAUT-IL EN DÉCRYPTER LEUR FONCTIONNEMENT MOLÉCULAIRE ET EN ANALYSER LEUR PHYSIOLOGIE.
C’est une découverte qui date de 1940 : les microalgues peuvent être utilisées pour la production d’hydrogène.
Depuis cette période, la recherche n’avait pas beaucoup progressé par manque d’intérêt et de financement dans ce secteur. Mais changement climatique oblige, de nouvelles sources de production d’hydrogène vertueuses sont désormais recherchées et prisées, principalement à des fins énergétiques.
Plusieurs chercheurs du laboratoire Biologie des Organismes Stress Santé Environnement (BiOSSE) l’ont compris et consacrent leurs travaux à améliorer la production et l’extraction de biomolécules de microalgues, dont l’hydrogène.
« Dans leur quotidien, les microalgues produisent des sucres simples qu’elles peuvent facilement utiliser », débute Benoît Schoefs, enseignant-chercheur en biologie et physiologie végétales. « Mais lorsqu’elles sont soumises à un stress, elles réorientent leur métabolisme et elles commencent à produire des molécules de réserve d’énergie, dont des lipides. Pour passer d’un métabolisme à l’autre, il existe toute une série d’aiguillages à activer. C’est l’identification des aiguillages qui est l’objet de nos recherches ».
De vraies usines cellulaires
Complice de Benoît Schoefs quand il s’agit de stresser des microalgues, Justine Marchand enseignante-chercheuse en biologie moléculaire, ajoute : « Nous ne connaissons pas encore les régulateurs des aiguillages agissant au sein du métabolisme des microalgues. C’est la raison pour laquelle nous décryptons le fonctionnement des cellules. Notre objectif est de transformer ces microalgues en usines cellulaires pour les cultiver et les amener à produire des molécules à façon (lipides, pigments, hydrogène). Une thèse en collaboration avec l’Institut des Molécules et Matériaux du Mans (IMMM - UMR CNRS 6283) a d’ailleurs démarré sur le sujet il y a six mois : l’idée est d’encapsuler les microalgues. Enfermées, elles peuvent se multiplier et produire de l’hydrogène ».
Benoît Schoefs souligne que produire de l’hydrogène à l’aide d’un organisme biologique est la seule méthode qui permet de ne pas émettre de carbone, voire d’en capter grâce à la photosynthèse. Toutefois, stresser des microalgues revient à leur faire réaliser des opérations de survie. Certes, elles se mettent à produire les biomolécules d’intérêt, mais dans le même temps, elles ont tendance à cesser leur multiplication ». Stresser les microalgues tout en les gardant en vie semble donc être tout un art. Justine Marchand et Benoît Schoefs développent également des méthodes de « traite » ou extraction biocompatible des microalgues, plus respectueuses de l’environnement, afin d’extraire les molécules produites. Les bases du procédé de traite ont fait l’objet d’un dépôt de brevet. Les travaux se poursuivent dans le cadre d’un programme international de recherche franco-indien, et bénéficient, comme la production de biohydrogène, d’un financement de pré-maturation de la SATT Ouest Valorisation. « En collaboration avec deux industriels indiens, nous cherchons à produire des pigments à haute valeur ajoutée, notamment des caroténoïdes », détaille Benoît Schoefs.
Et plus localement, un plateau innovant facilitant la croissance des microalgues a été développé, en partenariat avec l’entreprise MNCC, grâce à un financement de la Région des Pays de la Loire, et installé au laboratoire.
+ d’infos sur le projet ?
CHERCHEURS : Justine MARCHAND, Benoît SCHOEFS
NOMS DES PROJETS : AGITER, PPMB et production bioH2
LABORATOIRES :
BiOSSE | Biologie des Organismes Stress Santé Environnement
IMMM | Institut des Molécules et Matériaux du Mans [ UMR CNRS 6283 ]
DNM | Diatom Nanoengineering and Metabolism Lab
Gour University (Sagar University - India)
